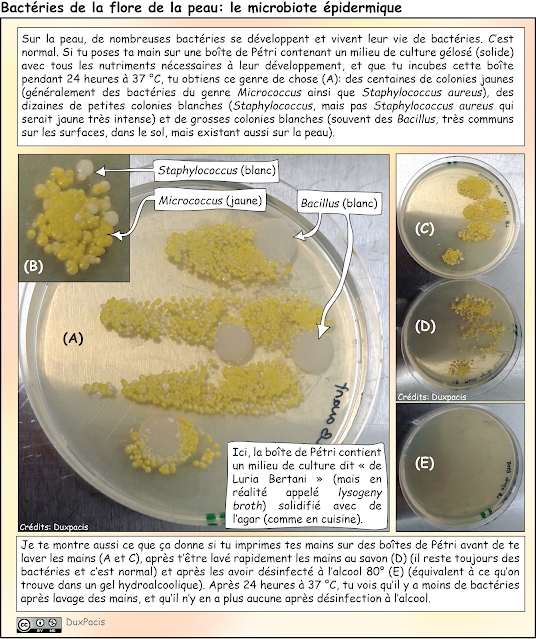

Safari microbien — Episode 3 : Le monde foisonnant du sol, et tout ça « en pratique »
Tu ne t’en rends peut-être pas compte, chère lecteur/chère lectrice, mais des milliards — voire des milliers de milliards — d’organismes te côtoient à tout instant. Partout. Dans l’eau, l’air, sur la peau, dans ton corps, etc. Cela représente des millions d’espèces. Beaucoup de monde, donc. La diversité microbienne dans l’environnement est proprement gigantesque. Si tu regardes en France[1], on dénombre des centaines de milliers d’espèces animales et de plantes, mais ceci ne représente qu’une minuscule fraction des formes vivantes. L’essentiel est invisible. Les microorganismes invisibles à l’œil nu représentent une biomasse plus gigantesque encore. Si tu considères la « biodiversité » comme le nombre d’espèces différentes (ce qui est discutable et discuté, voir[2]), alors les bactéries, les champignons, les archées, etc. représentent une biodiversité énorme. D’ailleurs, tu remarqueras que le terme « archées » (prononcer [arké]) t’es probablement complètement inconnu, alors que ces organismes unicellulaires qui ressemblent à des bactéries — mais n’en sont pas — sont très nombreux et très présents sur Terre.
Petit survol de ce qu’on trouve dans le monde de la Microbie
Il est peut être utile, à ce stade, que je te fasse un petit résumé des différents types d’organismes qui existent actuellement sur la planète. Evidemment, on peut les classer toute cette gigantesque diversité dans tout un tas de classes, de familles, de genres, mais en dépit de leurs morphologies, métabolismes, modes de vie, etc. très hétéroclites, ont peut les ranger dans des catégories plus vastes si l’on prend en compte la façon dont son organisées leurs cellules. Il y a ainsi deux types d’organismes : 1) les eucaryotes qui possèdent des cellules parfois très grandes, qui ont surtout la particularité de posséder un noyau membranaire renfermant l’ADN ; 2) les procaryotes qui possèdent généralement des cellules plus petites (de l’ordre de 0,2 à 1 ou 2 micromètres en moyenne) et qui ne disposent pas de structure équivalente au noyau.
Les animaux, les plantes, les champignons et un certain nombre d’unicellulaires (constitués d’une seule cellule) sont tous des eucaryotes, tandis que les bactéries et leurs cousines les archées sont des procaryotes, généralement unicellulaires (mais il peut y avoir des procaryotes multicellulaires). Dans l’univers de la Microbie (des microorganismes), on trouve donc des eucaryotes unicellulaires, comme certains champignons, des organismes très divers qu’on appelle des protistes, mais aussi tout une diversité de bactéries et d’archées. Evidemment, il y a aussi les virus, archétype s’il en est de l’entité biologique microscopique.
Faisons un tour dans la Microbie en pratique
Pour t’illustrer la diversité microscopique gigantesque qui te côtoie, j’ai choisi l’exemple du sol — disons ce qu’on trouve dans la terre d’un jardin. Je te donnerai d’autres exemples bientôt, mais on va commencer par le sol. C’est plus simple.
![]() |
| Figure 1 |
Prélevons un peu de terre dans un potager tout ce qu’il y a de plus normal. Comme sur la figure 1. Tu ne vois rien, à part de la terre. Mais dedans, dans quelques centaines de milligrammes, il y a des milliers d’organismes microscopiques. On pourrait observer tout ça au microscope. Je t’avais d’ailleurs déjà donné un exemple avec un échantillon d’eau d’une mare dans l’épisode 1. Mais dans ce cas, on avait des organismes assez gros (algues, paramécies, etc.), bien plus gros que des bactéries moyennes. Ces dernières sont beaucoup plus difficile à observer avec le type de microscope que j’avais utilisé, sans aucune coloration pour favoriser leur détection.
De plus, c’est parfois compliqué, la microscopie, et t’es pas toujours certain.e qu’il y ait beaucoup de microorganismes à voir. Avant ça, tu peux tenter de les « voir » à l’œil nu — du moins les « colonies » qu’ils forment — en les cultivant sur boîte de Petri (Figure 2). D’ailleurs, je te renvoie à l’épisode 2 pour comprendre tout ça un peu mieux si jamais tu n’en as pas l’habitude.
![]() |
| Figure 2 |
Mais attention ! Ce que cela signifie, c’est que tu pourras « voir » seulement les organismes capables de croître sur les milieux nutritifs que tu utilises et dans les conditions de température, pression, humidité, etc. que tu as choisies. On estime qu’on peut cultiver en laboratoire seulement 1 % des microorganismes présents dans l’environnement[3][4]. Le reste existe, vit un peu partout mais nécessite soit des conditions que tu ne peux pas reproduire, soit la présence d’autres organismes (symbioses).
Cultiver les microorganismes du sol : préparation des échantillons
Revenons à nos moutons. Ici, j’ai suspendu les 200 mg d’échantillon de terre dans 1 mL (millilitre) de solution saline — qui contient du phosphate et du sel, NaCl, à pH neutre — en mélangeant bien grâce à un agitateur qu’on appelle un vortex ; comme sur cette vidéo.
Le « phosphate » (H2PO4) joue ici le rôle de « tampon », c’est-à-dire une substance qui régule le pH. Le sel (NaCl, chlorure de sodium ou sel commun, comme celui que tu utilises pour saler tes plats), c’est pour réguler la pression osmotique ou, dit autrement, pour éviter que les cellules bactériennes n’éclatent dans de l'eau pure.
La suspension que j’obtiens est très concentrée (ce que tu peux voir à la coloration), donc j’ai prélevé 0,1 mL (ce qui correspond à 100 microlitres) avec une micropipette, que j’ai transférés dans un tube contenant 0,9 mL de solution saline. Autrement dit, j’ai placé mes 0,1 mL d’échantillon dans un volume de liquide final dix fois plus grand (0,1 mL + 0,9 mL = 1 mL). Tout ce qui se trouvait dans mon échantillon est donc maintenant réparti dans un espace liquide dix fois plus grand, et est de ce fait dix fois plus « dispersé ». On dit que l’échantillon est dilué 10 fois. Il est dix fois moins concentré. Tu vois d’ailleurs que c’est moins coloré.
J’ai recommencé avec ce tube dilué 10x, et j’en ai transféré 0,1 mL dans un nouveau tube contenant déjà 0,9 mL de solution saline. Encore une dilution par 10. Donc, maintenant, l’échantillon est dilué 100 fois. C’est celui-là qui va nous intéresser.
J’ai utilisé des boîtes de Pétri (3 boîtes) remplies chacune avec un milieu de culture gélosé différent (c’est précisé sur une illustration un peu plus loin). J’ai étalé 0,1 mL de l’échantillon dilué 100x sur chacune de ces boîtes. Pour ce faire, je dépose ces 0,1 mL sur la gélose, et j’étale le tout à l’aide d’une petite raclette (on appelle ça un râteau). Comme sur cette vidéo.
Finalement, j’ai disposé les 3 boîtes dans un incubateur fermé à 30 °C pendant 24 heures avant de les sortir et de les observer.
Cultiver des microorganismes du sol : « voir » les bactéries
Et voilà ce que tu peux voir après cette période d’incubation. Sur les milieux, tu as des colonies qui apparaissent (Figure 3). Que sont ces colonies ?
En fait, dans l’échantillon, il y a des milliers de bactéries, de champignons microscopiques, de spores de champignons et/ou de bactéries, et de microorganismes divers —amibes, archées, etc. La majorité n’est pas cultivable dans les conditions de mes géloses, n’oublie pas. Sur ces 3 milieux, seules bactéries et champignons croissent. Chaque colonie correspond à un endroit où 1 seule bactérie ou champignon unicellulaire qui se trouvait dans l’échantillon est tombé et s’est divisée en millions de clones. Cette colonie devient visible à l’œil nu. Je t’ai déjà expliqué ça dans l’épisode 2, mais la figure 4 reprend ça dans le cas des bactéries.
![]() |
| Figure 4 |
Après 24h, si tu regardes de plus près, avec une loupe binoculaire, tu peux voir que ces organismes forment alors des colonies aux formes, tailles, textures, architectures, couleurs et odeurs différentes (Figure 5). Si tu es spécialiste, tu peux même déterminer à qui tu as à faire. Là, j'ai utilisé une loupe binoculaire de laboratoire, qui est couplée à une caméra permettant de prendre des photos, ce qui m'a permis de documenter les observations et les morphologies des colonies avec des grossissements plus importants. Tu peux constater que par rapport à ce que tu vois à l'oeil nu (Figure 3), les colonies peuvent présenter tout un tas de morphologies et de caractéristiques de texture que tu ne peux pas distinguer sans la loupe.
![]() |
| Figure 5 |
Chacune de ces colonies est constituée de millions de cellules bactériennes entassées au même endroit ou de chapelets de cellules (champignons filamenteux). Avec une loupe binoculaire, tu ne peux pas voir les cellules bactériennes individuelles, elles sont trop petites (0.5 à 2 µm en moyenne). Pareil pour les champignons, les cellules sont trop petites. Pour les voir, il faudrait un microscope. Là, le but n’était que de te montrer la morphologie des colonies.
_________________________________________________________________________
Si tu replaces les boîtes de culture dans l’incubation pour 24 heures supplémentaires, les colonies deviennent beaucoup plus grandes, certaines encore plus étalées et surtout les couleurs, les textures, les formes et les odeurs sont plus prononcés (Figure 6). En réalité, chaque espèce microbienne développe des colonies aux propriétés morphologiques différentes, et cela permet, en première instance, d’identifier certaines d’entre elles — mais attention, cela ne suffit pas à en être certain, il y a d’autres techniques pour le faire.
![]() |
| Figure 6 |
Bref, tu vois que la diversité de microorganismes dans 200 mg de terre, c’est déjà énorme. Il y a là des dizaines d’espèces différentes. Et là, il n’y a que les espèces qui « poussent » sur ces milieux nutritifs. Il n’y a pas non plus les amibes, les cyanobactéries, etc.
Rappelle-toi que dans l’épisode 2, je t’avais raconté que la culture sur boîte gélosée avait permis l’isolement de bactéries pures, c’est-à-dire d’une espèce particulière et sans contamination par d’autres. Ici, tu as un bel exemple de ce fait. L’échantillon contenait des dizaines et des dizaines d’espèces microbiennes différentes. Beaucoup ne se sont pas développées, ce qui t’élimine déjà pas mal de contaminants. Ensuite, en étalant sur la gélose, des cellules individuelles se sont déposées un peu partout, et se sont multipliées. Chaque colonie représente donc un amas de clones de cette cellule de départ. On observe des colonies très différentes entre elles, correspondant à des amas de cellules d’espèces très différentes. Eh bien maintenant, je pourrais, à l’aide d’un cure-dent (ou de son équivalent de laboratoire), prélever un peu d’une colonie isolée, et cultiver les bactéries qui s’y trouvaient sur une autre boîte ou en milieu liquide. Et j’aurais ainsi ce qu’on appelle une culture pure, ne contenant que l’espèce en question et plus toutes celles qui la côtoyaient dans l’échantillon.
N’oublie pas non plus que j’avais dilué l’échantillon 100 fois, et que j’obtiens déjà des dizaines de colonies par boîte ; dans les 200 mg, il y avait donc 100 fois plus de monde. Ce serait pareil si j’essayais de voir ce qui se trouve dans un appartement, un bureau, etc. On peut faire le même exercice pour voir ce qui se développe quand on pose sa main sur une boîte de Pétri (Figure 7) sans s’être lavé les mains depuis 3 heures, après les avoir lavées au savon, ou après les avoir désinfectées au gel hydroalcoolique. Beaucoup de monde aussi ! Au passage, tu « vois » que le gel hydroalcoolique éradique vraiment les bactéries de la peau.
![]() |
| Figure 7 |
__________________________________________________________________________
Commentaire de la figure 7: Sur la peau, de nombreuses bactéries se développent et vivent leur vie de bactéries. C’est normal. Si tu poses ta main sur une boîte de Petri contenant un milieu de culture gélosé (solide) avec tous les nutriments nécessaires à leur développement (ici c'était un milieu "lysogenic broth"), et que tu incubes cette boîte pendant 24 heures à 37 °C, tu obtiens ce genre de chose (A): des centaines de colonies jaunes (généralement des bactéries du genre Micrococcus ainsi que Staphylococcus aureus), des dizaines de petites colonies blanches (Staphylococcus, mais pas Staphylococcus aureus qui serait jaune très intense) et de grosses colonies blanches (souvent des Bacillus, très communs sur les surfaces, dans le sol, mais existant aussi sur la peau).
Je te montre aussi ce que ça donne si tu
imprimes tes mains sur des boîtes de Petri avant de te laver les mains (A et
C), après t’être lavé rapidement les mains au savon (D) (il reste toujours des
bactéries et c’est normal) et après les avoir désinfecté à l’alcool 80° (E)
(équivalent à ce qu’on trouve dans un gel hydroalcoolique). Après 24 heures à
37 °C, tu vois qu’il y a moins de bactéries après lavage des mains, et qu’il
n’y en a plus aucune après désinfection à l’alcool.
____________________________________________________________________________
Il y a des centaines d’espèces de bactéries différentes sur la peau humaine, et c’est normal. C’est ce qu’on appelle le microbiote (microbiome, en anglais) de la peau[5][6][7]. Cela représente des milliards de cellules bactériennes, en tout. Sans elles, point de bonne santé. Et puis ne parlons pas de ce qui circule dans l’air. Spores de champignons filamenteux (moisissures) et autres formes de dissémination de microorganismes. Tu les respires à longueur de journée, ce qui t’expose au risque qu’ils s’y développent. Je t’en parlerai bientôt aussi. Dans l’air continental, par exemple, tu rencontres entre 1000 à 10 000 spores de champignons par mètre cube d’air[8][9]. A chaque inspiration, tu en inhales quelque chose comme une à quelques dizaines (en extérieur) ; elles finissent dans tes alvéoles pulmonaires.
Et là, on n’a pas parlé des virus du sol, de l’air ou qui se trouvent sur toi, en toi. On ne peut pas les « cultiver » sur boîte: impossible, ils ne sont pas autonomes. Mais ils sont des milliards. Je t’en parlerai une prochaine fois.
Pourquoi tout ces trucs — y compris les organismes qui vivent sur et en toi — ne parviennent pas à t’envahir, à se développer et à utiliser ton organisme comme réserve de nutriments ou usine à reproduction ? Parce que tu possèdes un système immunitaire. A cause de ces microorganismes, ce système immunitaire n’est jamais au repos. Jamais en veille. Les seules fois où tu remarques une infection, c’est parce que le système immunitaire n’est pas assez rapide ou que les envahisseurs parviennent à lui échapper. On va bientôt parler de système immunitaire. Sois patient.e.
J’espère que ça t’a plu. Sur ce, je te dis à bientôt, et comme d’habitude, je te mets les sources en-dessous.
Références
[1] Le travail de référencement des espèces sur le territoire français est publié par le Muséum d’Histoire Naturelle : https://inpn.mnhn.fr/telechargement/referentielEspece/taxref/12.0/menu. Un résumé a été publié sur Futura-Sciences ici: https://www.futura-sciences.com/planete/questions-reponses/nature-biodiversite-y-t-il-especes-france-monde-10405/
[2] Le terme « biodiversité », en réalité, ne doit pas se référer qu’au nombre d’espèces, car c’est une représentation réductrice et trompeuse. Il faut aussi prendre en compte la diversité génétique, le nombre d’individus, etc.
[3] Steen AD, Crits-Christoph A, Carini P, DeAngelis KM, Fierer N, Lloyd KG, Cameron Thrash J. High proportions of bacteria and archaea across most biomes remain uncultured. ISME J. 2019 Dec;13(12):3126-3130. doi: 10.1038/s41396-019-0484-y
[4] Martiny AC. The '1% culturability paradigm' needs to be carefully defined. ISME J. 2020 Jan;14(1):10-11. doi: 10.1038/s41396-019-0507-8.
[5] Byrd AL, Belkaid Y, Segre JA. The human skin microbiome. Nat Rev Microbiol. 2018 Mar;16(3):143-155. doi: 10.1038/nrmicro.2017.157.
[6] Saheb Kashaf S, et al Integrating cultivation and metagenomics for a multi-kingdom view of skin microbiome diversity and functions. Nat Microbiol. 2022 Jan;7(1):169-179. doi: 10.1038/s41564-021-01011-w.
[7] Grice EA, Segre JA. The skin microbiome. Nat Rev Microbiol. 2011 Apr;9(4):244-53. doi: 10.1038/nrmicro2537. Erratum in: Nat Rev Microbiol. 2011 Aug;9(8):626
[8] Fröhlich-Nowoisky J, Pickersgill DA, Després VR, Pöschl U. High diversity of fungi in air particulate matter. Proc Natl Acad Sci U S A. 2009 Aug 4;106(31):12814-9. doi: 10.1073/pnas.0811003106.
[9] Bowers RM, Clements N, Emerson JB, Wiedinmyer C, Hannigan MP, Fierer N. Seasonal variability in bacterial and fungal diversity of the near-surface atmosphere. Environ Sci Technol. 2013;47(21):12097-106. doi: 10.1021/es402970s

Aucun commentaire:
Enregistrer un commentaire